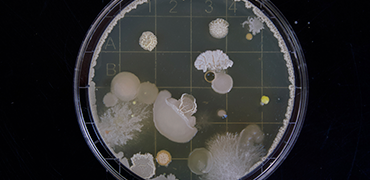

Skabelon
Skabelon til et explainer-format
Dette er en testside, der skal vise nogle af de muligheder der er på artikelsider.
Lorem ipsum dolor sit amet, consectetur adipiscing elit. Quisque ullamcorper dictum purus nec porttitor. Nulla porta ornare est, nec ultrices nunc auctor sed. In id molestie nunc, sit amet vehicula nisi. Praesent vitae semper tortor, ut mollis magna. Donec bibendum tristique urna, vel porttitor orci bibendum ut. Suspendisse lacinia ornare pulvinar. Sed consequat mauris nec enim placerat interdum.

Labeltekst
1: Spørgsmål, titel eller lignende
Teasertekst skrives her - kan også udelades.
Mauris convallis arcu quis diam cursus ultricies. In laoreet, elit sed dictum egestas, neque risus aliquet lorem, non vulputate est metus sed tortor. Fusce volutpat mattis leo, et gravida turpis ullamcorper eu.
Phasellus dignissim mauris tincidunt, commodo mauris mollis, interdum dui. Pellentesque habitant morbi tristique senectus et netus et malesuada fames ac turpis egestas. Quisque nulla mi, mollis non erat sit amet, mollis sollicitudin lacus. Pellentesque non sodales augue.

Labeltekst
2: Titel på boksen
Teasertekst skrives her - kan også udelades.
Mauris convallis arcu quis diam cursus ultricies. In laoreet, elit sed dictum egestas, neque risus aliquet lorem, non vulputate est metus sed tortor. Fusce volutpat mattis leo, et gravida turpis ullamcorper eu.
Phasellus dignissim mauris tincidunt, commodo mauris mollis, interdum dui. Pellentesque habitant morbi tristique senectus et netus et malesuada fames ac turpis egestas. Quisque nulla mi, mollis non erat sit amet, mollis sollicitudin lacus. Pellentesque non sodales augue.

Labeltekst
3: Endnu en titel på boksen
Teasertekst skrives her - kan også udelades.
Mauris convallis arcu quis diam cursus ultricies. In laoreet, elit sed dictum egestas, neque risus aliquet lorem, non vulputate est metus sed tortor. Fusce volutpat mattis leo, et gravida turpis ullamcorper eu.
Phasellus dignissim mauris tincidunt, commodo mauris mollis, interdum dui. Pellentesque habitant morbi tristique senectus et netus et malesuada fames ac turpis egestas. Quisque nulla mi, mollis non erat sit amet, mollis sollicitudin lacus. Pellentesque non sodales augue.
Maecenas rutrum, ante sit amet viverra luctus, mi eros commodo dolor, in ullamcorper justo augue sed lorem. Maecenas pulvinar lobortis odio, sed fermentum justo sodales quis. Vestibulum ante ipsum primis in faucibus orci luctus et ultrices posuere cubilia curae; Fusce ultricies sapien justo. Vestibulum mi arcu, aliquam ac enim nec, consequat rhoncus metus.
Faktaboks kan placeres her
Nam a fringilla est, laoreet pharetra arcu. Phasellus ante elit, venenatis sed dui sed, vehicula dignissim massa. In volutpat eros nulla, quis sollicitudin diam dignissim ut. Nullam rutrum dui sit amet odio sollicitudin, at vulputate lorem finibus.